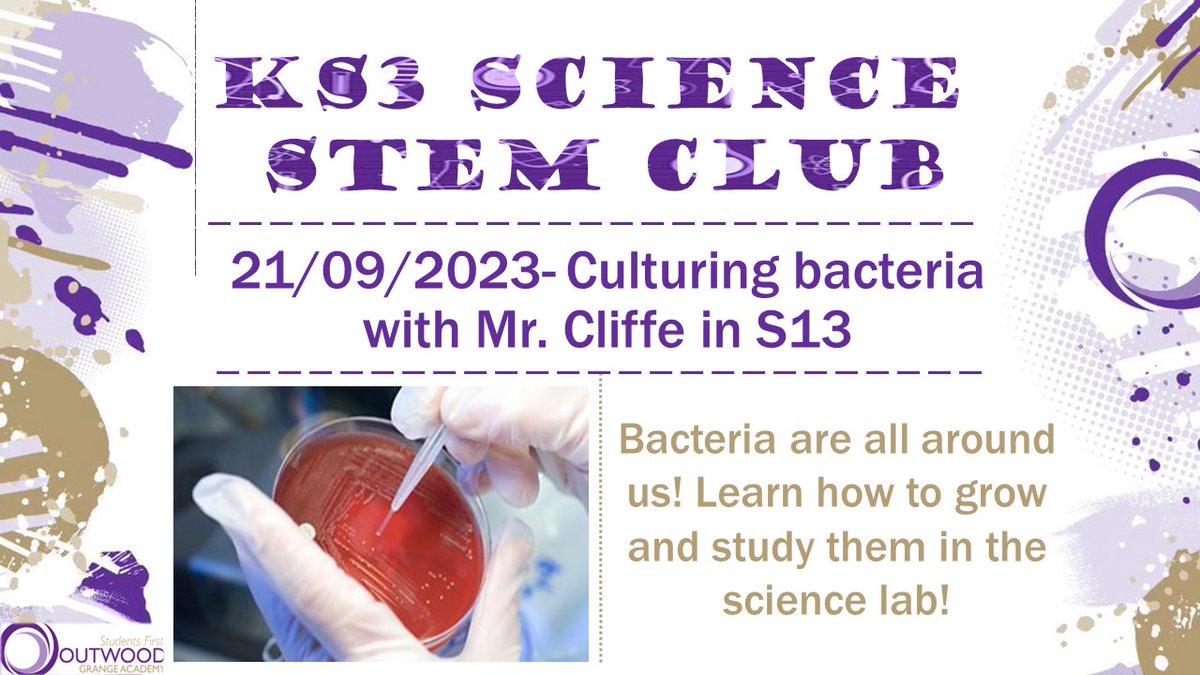
OGA Science tweet media

OGA Science
2.1K posts


What a lovely evening to launch the preparation for November assessments. If you didn't manage to collect some 'Cheeky One Markers', please complete the Google Form on your Science Google Classroom.
Outwood Grange Academy@OGACADEMY
A fantastic turnout of parents and students at our Y11 information tonight. Staff from our core subjects provided key information to help our students and families prepare for mock exams starting in 5 weeks. sites.google.com/grange.outwood… #catchtheenergy 🧠🤩
English

Our KS3 STEM club had an amazing time attempting to make a rainbow in a test tube. Join us next Thursday for a new challenge! @OGACADEMY #STEM #dowell


English

Looking forward to meeting Year 6 at @OGACADEMY Open Evening. Will you accept the challenge?


English

This week we launch our KS4 enrichment to support Year 10 & 11 with their GCSE Sciences. This week we will be reviewing elements of B1, C1 & P1 📖 @OGACADEMY #dowell
English

So excited to announce the launch of our STEM club this week for Years 7-9! Join @cliffe_mr culturing bacteria on Thursday 🧫 @OGACADEMY #dowell #STEM
English
OGA Science retweetledi

Y11 focused and engaged @OGA_Sci in preparation for their Biology exam on Tuesday #motivated #proud 🧫 🧬



English

We are looking for someone to lead the most amazing team of science teachers, 121 tutors and science technicians from September 2023. tes.com/jobs/vacancy/h…
English

@laurenbm90 You would have loved today - the post 16 restaurant was buzzing. Don’t know why we’ve not thought of doing it in there before.
English

This was lovely to come home to tonight. Classroom Champion x 2 - English & Physics 👏👏👏👏 @OGAEnglish @OGA_Sci

English

Thinking about all the y13 @OGAPost16 students this evening and hoping all your plans come together for you when you open your envelopes and UCAS emails tomorrow.
It’s been a tough 3 years and you should be so proud of yourselves.
One more sleep. 🤞🏻
English

Congratulations! Super proud of you. I think it was that science fair project that did it. 😉
You know where we are for a careers talk whenever you’re in Wakefield. 😊
alexandra horler@al_xh_
i have a pharmacy degree?? i have a 2:1 pharmacy degree?? i’m going to be a pharmacist 😭😭 (@OGA_Sci thank you for teaching me to make aspirin it definitely helped in the long run)
English
OGA Science retweetledi

Finished off ECT year one at @OGACADEMY, it's been full of ups and downs, but I'm already excited for year 2! Couldn't ask for a more supportive team than @OGA_Sci! #ECT #Chemistry #teacher #education
English

@beccamerlene @OutwoodScience @OGA_Sci @OGAPost16
Outwood alumni to the lakes! Graduates on the same day in 2017 and 2022! 🎓
What a catch up we have ahead - I’ve aged 😂
English

After leaving school five years ago, I have finally graduated medicine to find out a school friend (who also graduated today) will be joining me in Carlisle for FY1! What are the chances @Fran_Liz_Law @OutwoodScience
English

This week will be great. But next week is the science taster sessions so will be even better! 🥼🧪🧫👩🏻🔬🧑🏽🔬
Outwood Grange Academy@OGACADEMY
We are looking forward to seeing the first of our new Y7 students tomorrow. Please remember to arrive between 8:45-9am. The turning circle will be open for the students being dropped off.
English




